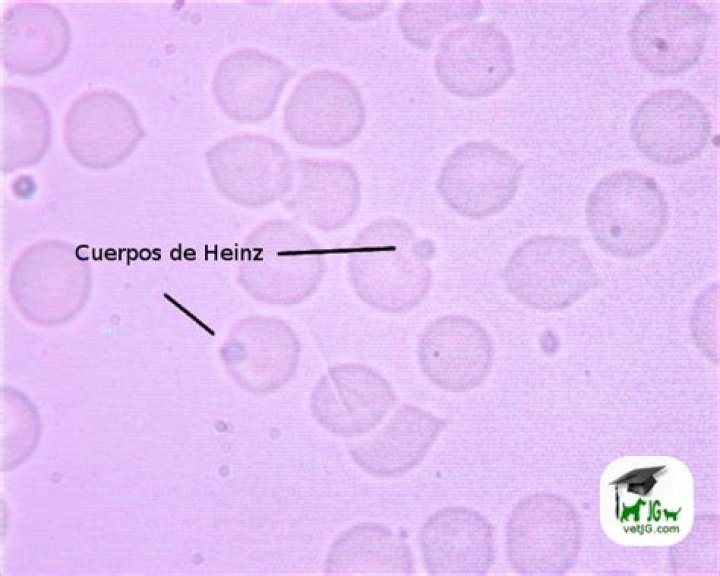

¿Qué es el cuerpo de Heinz

Sophia Edwards
Published Mar 04, 2026
Los cuerpos de Heinz son pequeñas inclusiones, redondas y retráctiles que se encuentran en la periferica de las células. Están formados por globina desnaturalizada que se produce cuando se destruye lla hemoglobina
¿Qué es un cuerpo de Heinz?
Los cuerpos de Heinz son acumulaciones de hemoglobina desnaturalizada en el interior de los eritrocitos que se forman debido a fenómenos de oxidación de esta hemoglobina.
¿Qué es el cuerpo de Howell Jolly?
Los cuerpos de Howell Jolly, son remanentes nucleares intraeritrocitarios que se observan en el frotis de sangre periférica con tinción de Wright. 1: Frotis de sangre periférica donde se observan (Flechas), inclusiones basófilas intraeritrocitarias características de los cuerpos de Howell Jolly.
¿Cómo ver cuerpos de Heinz?
Sí se visualizan con tinciones vitales, adoptando un color azul intenso si se utiliza el colorante azul de cresil brillante. O adoptando un color púrpura si se utiliza el colorante cristal violeta. La presencia de estos cuerpos no es normal, ya que la hemoglobina precipita porque está alterada.¿Qué significa Crenocitos en sangre?
Crenocitos (Fig. 10): Son aquellos que presentan membrana ondulante e irregular. Se encuentran en algunas anemias hemolíticas. Este fenómeno puede ser inducido in vitro exponiendo los hematíes a una solución hipertónica.
¿Qué es un cuerpo de dohle?
Cuerpos de Döhle. Los cuerpos de Döhle son áreas no muy notables, no granulares de tinción azul encontradas en la periferia del citoplasma de neutrófilos en infecciones y otros estados tóxicos. Conforman agregados de retículo endoplásmico rugoso.
¿Qué produce la talasemia?
La talasemia es un trastorno de la sangre hereditario (es decir, se pasa de los padres a los hijos a través de los genes) que ocurre cuando el cuerpo no produce la cantidad suficiente de una proteína llamada hemoglobina, una parte importante de los glóbulos rojos.
¿Cuáles son los tipos de hemoglobina que existen?
Existen muchos tipos diferentes de hemoglobina (Hb). Los más comunes son HbA, HbA2, HbE, HbF, HbS, HbC, HbH y HgbM. Los adultos sanos solo tienen niveles significativos de HbA y HbA2. Algunas personas también pueden tener pequeñas cantidades de HbF.¿Dónde se produce la eritropoyetina y cuál es su función?
La eritropoyetina (EPO) es una hormona producida principalmente por los riñones. Juega una función primordial en la producción de las células de la serie roja (hematíes o eritrocitos), que son las células encargadas de transportar oxígeno desde los pulmones hacia el resto del organismo.
¿Dónde se encuentra la célula Eritrocito?Los eritrocitos están presentes en la sangre y transportan el oxígeno al resto de las células del cuerpo.
Article first time published on¿Cuándo se presentan los cuerpos de Howell Jolly?
Las inclusiones tipo cuerpos de Howell–Jolly se correlacionan con el síndrome mielodisplásico. Las inclusiones tipo cuerpos de Howell–Jolly han sido asociadas previamente con pacientes infectados por el virus de la inmunodeficiencia humana (VIH), que toman medicamentos antivirales y que se encuentran inmunosuprimidos.
¿Cómo se cura la anisocitosis?
Si es una anisocitosis causada por anemia no complicada, puede ser tratada con suplementos de hierro. Si se determina que es por falta de vitaminas se le dará el aporte necesario de estos nutrientes y si fuese por otro tipo de anemia, entonces el tratamiento será más complejo y de por vida.
¿Cómo se reporta la anisocitosis?
1 Anisocitosis: cuando los hematíes muestran diferentes tamaños o diámetros en una misma extensión se refiere la presencia de anisocitosis, que puede ser moderada o severa. Su hallazgo es muy frecuente, inespecífico y constante en pacientes transfun- didos.
¿Qué significa presencia de eritroblastos?
Los eritroblastos son células precursoras de los eritrocitos o glóbulos rojos en la eritropoyesis.
¿Qué enfermedades detecta el frotis?
- Anemia.
- Anemia falciforme.
- Anemia hemolítica: Tipo de anemia en el que los glóbulos rojos son destruidos antes de poder reemplazarse. Esto hace que el cuerpo se quede sin suficientes glóbulos rojos sanos.
- Talasemia.
- Enfermedades de la médula ósea.
¿Qué es el Rouleaux en sangre?
Descripción: en el fenómeno de rouleaux los eritrocitos aparecen en el extendido de sangre periférica organizados uno tras otro, su- perpuestos por las caras bicóncavas, como se observa en la figura 2. Sinónimos: formación de pilas de mone- das.
¿Cuánto tiempo puede vivir una persona con talasemia?
Si reciben unos cuidados médicos regulares, las personas que padecen una beta talasemia intermedia o mayor pueden vivir hasta que tienen entre cincuenta y sesenta años de edad.
¿Qué puedo tomar para la talasemia?
Es frecuente que a las personas con talasemia se les recete un suplemento de vitamina B, conocido como ácido fólico, para ayudar a tratar la anemia. El ácido fólico puede ayudar a la producción de glóbulos rojos. El tratamiento con ácido fólico generalmente se realiza además de otras terapias.
¿Cuántos tipos de talasemia hay?
Existen dos tipos principales de talasemia: La talasemia alfa ocurre cuando un gen o los genes relacionados con la proteína globina alfa faltan o han cambiado (mutado). La talasemia beta ocurre cuando defectos genéticos similares afectan la producción de la proteína globina beta.
¿Qué es una reacción Leucemoide?
Es un incremento de la cantidad de glóbulos blancos, lo cual puede simular una leucemia. La reacción se debe en realidad a una infección o a otra patología y no es un signo de cáncer. Los conteos sanguíneos generalmente retornan a la normalidad cuando se trata la enfermedad subyacente.
¿Cuántas plaquetas por campo es lo normal?
Resultados normales La cantidad normal de plaquetas en la sangre es de 150,000 a 400,000 plaquetas por microlitro (mcL) o 150 a 400 × 109/L.
¿Qué significa neutrófilos en cayado 0?
En situaciones de infección o inflamación su número aumenta en la sangre. En estos casos se observan algunos que son ‘inmaduros’ y se denominan cayados. En la analítica se indica en forma de porcentaje sólo cuando hay infección porque en condiciones normales su cifra es cero.
¿Qué órgano produce la eritropoyetina?
Acción de la EPO La EPO es producida inicialmente en el feto por el hígado y en el adulto por el riñón, su principal función es estimular la producción de eritrocitos y la concentración de oxígeno en los tejidos es la que regula su producción.
¿Cómo se produce la eritropoyetina?
La eritropoyetina (epoetina) es un producto endógeno que se produce normalmente en las células yuxtatubulares del riñón y en los macrófagos; su acción principal es estimular las células progenitoras eritroides, las cuales aceleran el proceso de división y diferenciación.
¿Cómo se obtiene la eritropoyetina?
La Eritropoyetina (EPO) es sintetizada por las células endoteliales de los capilares peritubulares en la corteza renal y actúa sobre receptores específicos expresados en la superficie de las células progenitoras eritrocíticas (Er-P) en la médula ósea.
¿Cómo se dice hemoglobina baja?
¿Qué es anemia? Si usted no cuenta con suficientes glóbulos rojos sanos, padece una condición llamada anemia. Esto significa que su sangre tiene niveles de hemoglobina (Hgb) más bajos de lo normal.
¿Cómo se compone la hemoglobina?
La hemoglobina está compuesta por una proteína denominada globina y un compuesto denominado hemo. El hemo está compuesto por hierro y un pigmento denominado porfirina, que le da a su sangre el color rojo. La hemoglobina cumple la función importante de transportar oxígeno y dióxido de carbono por medio de su sangre.
¿Qué tipo de proteína es la hemoglobina de la sangre?
La hemoglobina (Hb) es una proteína globular con una masa molecular de 64.4 kDa; es un tetrámero formado por la unión de cuatro cadenas polipeptídicas, dos de tipo α-globina de 141 aminoácidos (aa) y dos de tipo β-globina de 146 aa.
¿Qué tipo de célula es el eritrocito?
Los eritrocitos (glóbulos rojos o hematíes) son células anucleadas (sin núcleo), bicóncavas y cargadas de hemoglobina que transportan oxígeno y dióxido de carbono entre los pulmones y otros tejidos. Se producen en la médula ósea roja mediante un proceso llamado eritropoyesis.
¿Que transporta el eritrocito?
Los eritrocitos contienen una proteína llamada hemoglobina, que transporta oxígeno desde los pulmones a todas las partes del cuerpo.
¿Que hay dentro de un eritrocito?
Contiene un esqueleto de proteínas actina-espectrina conectada a las proteínas integrales de la membrana, banda 3 y glucoforina C vía las proteínas puente anquirina y banda 4.1. Lípidos. Prácticamente todos los lípidos del eritrocito maduro se encuentran en la membrana.



